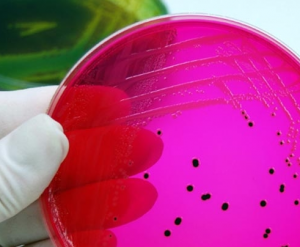

Основные симптомы сальмонеллеза у детей
Основные симптомы сальмонеллеза у детей включают следующее:
- Жар: дети с сальмонеллезом могут испытывать повышенную температуру тела, часто сопровождающуюся лихорадкой. Температура может достигать 39-40 градусов Цельсия.
- Боли в животе: дети могут жаловаться на боль в области живота, часто сопровождающуюся коликами или судорогами. Боли могут быть сильными и могут усиливаться после приема пищи.
- Диарея: сальмонеллез часто вызывает жидкий стул с интенсивным запахом. Диарея может быть частой и проявляться до 10-15 раз в день.
- Тошнота и рвота: дети с сальмонеллезом могут испытывать тошноту, а иногда и рвоту. Это может приводить к потере аппетита и дегидратации.
- Общая слабость: сальмонеллез может вызывать общую слабость, утомляемость и повышенную раздражительность у детей. Дети могут быть апатичными и неактивными.
Если ваш ребенок проявляет подобные симптомы, важно обратиться к врачу для получения диагностики и лечения. Сальмонеллез требует комплексного лечения, включающего прием антибиотиков и регидратацию
Как лечится сальмонеллез
Устранение сальмонеллы возможно только с помощью специальных антибиотиков. Подбор этих лекарств осуществляется только врачом после тщательной диагностики. Для предотвращения фатальных осложнений, младенцы и дети до 10 лет обязательно госпитализируются. При первых признаках заболевания необходимо немедленно вызвать скорую помощь. До приезда врача, чтобы предотвратить сильное обезвоживание организма ребенка, рекомендуется часто давать ему простые напитки, такие как вода или несладкий чай. Можно приготовить раствор, смешав чайную ложку соды, такое же количество соли, в полтора раза больше сахара (2 чайные ложки) и литр воды. Пока ждете приезда скорой помощи, предложите малышу пить этот раствор.
Симптомы заражения сальмонеллезом у детей
Инфекционное поражение сальмонеллами протекает тяжело и продолжительно. Длительность инкубационного периода зависит от возраста, состояния иммунитета и количества попавших в организм бактерий. Как правило, сальмонеллез у детей проявляется следующими симптомами:
- лихорадкой;
- потом;
- ознобом;
- гиподинамией;
- потерей аппетита;
- увеличением печени;
- гастритом;
- гемоколитом.
Клиническая картина при легкой форме заболевания
Симптомы при легкой форме сальмонеллеза включают в себя субфебрильную лихорадку, жидкий нечастый стул. Признаки интоксикации и дегидратации организма выражены слабо. Присутствует несильная приступообразная боль в животе. Кроме того, дети с этой формой заболевания отказываются от еды, жалуются на общую слабость. Легкая форма инфекции составляет около 40% всех случаев болезни.
При средней
Характеризуется выраженной лихорадкой (до 40 градусов), ознобом, потливостью, слабостью, головокружением. Присутствует выраженный диспепсический синдром: жидкий стул с примесью слизи и крови до 20 раз в сутки, частая, неукротимая рвота без облегчения. Дети жалуются на сильную схваткообразную боль в околопупочной области, которая сохраняется длительное время.
Проявления сальмонеллеза у детей разного возраста
Клиническая картина при поражении сальмонеллами у детей разных возрастов значительно отличается. Это обусловлено особенностями анатомического строения, физиологии и состоянием иммунной системы. Выделяют следующие отличия в разных возрастных группах:
- Новорожденные. При сальмонеллезе в первый месяц жизни явные признаки поражения желудочно-кишечного тракта отсутствуют, температура тела остается в пределах нормы. Мама отмечает отказ новорожденного от еды, недобор веса, бледность кожи, срыгивания, постоянное беспокойство и изменение формы родничка (он становится втянутым).
- Груднички. Сальмонеллез у детей до года проявляется рвотой, жидким, иногда зловонным поносом, отсутствием аппетита и резким подъемом температуры тела.
- Дошкольники. У детей от года заболевание развивается остро, характеризуется резким скачком температуры тела (38 – 38,5°C), многократной рвотой, поносом, болью в животе, метеоризмом. Пациенты жалуются на отсутствие аппетита, общую слабость.
Особенности течения разных типов сальмонеллеза у детей
В клинической практике выделяют несколько типов заболевания в зависимости от преобладающей клинической картины. Это:
- Желудочно-кишечный. Как правило, встречается у детей в возрасте до года. Для него характерны повышение температуры тела до 39-40 градусов, боль в животе, рвота, обильный водянистый стул, вздутие живота.
- Тифоподобный. Такая форма заболевания характерна для детей в возрасте от года до трех лет. Проявляется симптомами общей интоксикации (слабость, головная боль), сухостью во рту, увеличением языка, поносом, повышением температуры до субфебрильных значений (37-38 градусов), гепатомегалией (увеличением печени), высыпаниями.
- Септический. Редкая форма заболевания, встречается у грудничков и новорожденных. Септическая форма сальмонеллеза вызывает резкое повышение температуры тела до 40 градусов, рвоту, жидкий стул со сгустками крови и слизи, учащенное сердцебиение.
- Бактерионосительство. Носительство сальмонеллеза у детей наблюдается в период выздоровления пациентов. При этом клиническая картина сальмонеллеза отсутствует, бактерии обнаруживаются в пищеварительном тракте при лабораторных исследованиях. Выделяют хроническое носительство, котором микроорганизмы выделяются в окружающую среду более трех месяцев.
Диагностика
Чтобы поставить диагноз, требуется проведение различных процедур, т. к. сальмонеллез легко перепутать с другими заболеваниями. Для диагностики проводятся такие обследования:
- Анализ каловых масс.
- Общий анализ крови.
- Бактериальный посев. В каловых и рвотных массах можно обнаружить возбудителя сальмонеллеза. Если есть подозрение, что сальмонелла распространилась в другие органы, дополнительно делают посев мочи, желчи, кишечника. Результаты анализа готовятся7-8 суток. Когда ребенку требуется срочная помощь, этот метод не подойдет.
- Экспресс-диагностика. Проводят различные методы иммунохимического анализа на присутствие в крови антител к сальмонеллам. Метод можно использовать в качестве проверки наличия возбудителя в продуктах питания.
Первые симптомы
У ребенка с заражением начинается несварение желудка, которое перерастает в выраженные симптомы диспепсии. Это метеоризм, повышенное газообразование, острая диарея, боли в области живота. Сальмонеллез однозначно будет сопровождаться рвотой, которая вызывает полное обезвоживание детского организма
Важно медикаментозно нормализовать водный обмен. Стул при сальмонеллезе жидкий, имеет зеленоватый оттенок, зловонный запах
Вот другие симптомы:
- частое испражнение кишечника;
- рецидивирующие боли в животе;
- острая кишечная колика;
- высокая температура;
- повышенная нервозность;
- плохой сон малыша;
- сниженная физическая активность.
Дальнейшие действия и помощь
Пока врачи в пути, основной задачей родителей становится борьба с обезвоживанием организма ребенка, к которому приводят обильная диарея, рвота и высокая температура. Сильное обезвоживание представляет смертельную угрозу для малыша. К счастью, справиться с ним не так сложно.
Наиболее эффективный метод – интенсивно поить ребенка специальным солевым раствором. Это может быть аптечный порошок, растворенный в воде, или раствор, приготовленный самостоятельно по официальному медицинскому рецепту: в 1 литре простой чистой воды растворить 2 столовые ложки сахара и по 1 чайной ложке соли и соды.
Если же малыш отказывается пить такую, разумеется, не самую приятную на вкус смесь, то поите его любой другой жидкостью: водой, компотом, соком, морсом. И хотя это будет уже не так эффективно, но тоже действенно. Главное, чего вы должны достичь, это восполнить необходимое количество жидкости в детском организме.
Однако новорожденных младенцев и грудничков обычным способом напоить может быть невозможно. Поэтому наберите в обычный шприц (без иглы) солевой раствор, а затем вливайте его потихоньку малышу в уголок ротика.
Даже если сальмонеллез или другой вид кишечной инфекции протекает у ребенка в не слишком тяжелой форме, все же стоит на некоторое время перевести его на режим голодания и интенсивного потребления жидкости.
И хотя у детей острый инфекционный период протекает в течение 5-7 дней, если у вас получится давать ребенку достаточно жидкости, ему будет гораздо лучше уже через день или два.
Как лечить сальмонеллез у детей?

Лечение кишечной инфекции у детей, возбудителем которой является Salmonella, предусматривает такие мероприятия:
- остановка рвотного рефлекса и диареи;
- восполнение потерянной жидкости в организме больного;
- назначение антибактериальных препаратов;
- соблюдение диетического питания на протяжении лечения и периода реабилитации пациента.
- В первые часы поступления в больницу детям ставят капельницы, что позволяет предотвратить полное обезвоживание организма.
- Наряду с капельным восполнением жидкости врачи назначают прием солевых растворов «Регидрон», «Хумана Электролит», «Глюкосолон». В их составе содержится глюкоза, поваренная соль и регулятор кислотно-щелочного баланса – калия хлорид. Пить растворы нужно в большом количестве, что позволяет быстро вывести токсины из организма.
- В течение первых пяти дней болезни рекомендуется прием адсорбирующего препарата «Атоксил» в виде порошка, который разводят в воде и принимают, чередуя с солевыми растворами.
- В первый день обострения болезни рекомендуется голодание.
- При легкой форме сальмонеллеза достаточными являются обильное питье и диетическое питание. При остром протекании болезни назначается антибактериальная терапия с применением антибиотиков «Левомитицин», «Полимиксин», «Ампициллин». Антибактериальная терапия длится около десяти дней.
- Для восстановления работы пищеварительного тракта назначаются ферменты, принимаемые вместе с едой «Панзинорм», «Креон-1000», «Фестал» или «Мезим».
- Для восстановления благоприятной микрофлоры кишечника прописываются пробиотики «Лактовит», «Линекс», «Бификол».

Лечение сальмонеллеза должно проходить в стационаре инфекционной больницы. Самостоятельная терапия может привести к ухудшению состояния и летальному исходу. Обращаться за помощью нужно при неоднократной рвоте и частой дефекации на фоне повышенной температуры тела.
Кишечные бактерии очень быстро размножаются и поражают весь организм, поэтому затягивание времени – это создание благоприятной среды для колонизации сальмонелл.

- У грудничков первых месяцев жизни заболевание протекает в острой форме. Терапия может длиться от месяца до полугода. При их лечении обязательной является антибиотикотерапия.
- У пациентов детского возраста (1-5 лет) сальмонеллез протекает также тяжело. У детей этого возраста наблюдается слабая кислотная среда желудка, что является благоприятным фактором для размножения бактерий.
- У пациентов в возрасте от 5 до 15 лет заболевание лечится в течение 10-15 дней. Антибиотики в большинстве случаев назначаются в качестве профилактики.
При соблюдении всех рекомендаций компетентных врачей лечение легкого и острого сальмонеллеза у детей гарантирует отсутствие побочных эффектов терапии. После выписки из лечебного учреждения дети в течение четырех месяцев сдают периодические анализы на посев сальмонелл.
Виды и признаки
Бактерии живут, как правило, в желудочно-кишечном тракте человека, но обладают способностью внедряться и паразитировать в клетках. Поэтому при несостоятельном иммунитете они могут с кровью разноситься по всему организму, что обуславливает различные формы заболевания.
Локализованная форма
Локализованная или гастроинтестинальная форма может быть представлена следующими вариантами:
Локализованная или гастроинтестинальная форма может быть представлена следующими вариантами:
- Гастроэнтеритическим;
- Гастроэнтероколитическим;
- Гастритическим.
Заболевание начинается, проявляясь характерными для всех кишечных инфекций симптомами – повышением температуры до 39°C и признаками общей интоксикации – слабостью, головной болью.
Далее появляется рвота, тошнота, боли в животе и жидкий стул. Симптомы могут варьироваться, в зависимости от того, какая часть кишечника поражена.
Гастроэнтеритический вариант
При этом варианте болезни, помимо общих признаков, присутствуют :
- схваткообразные боли, разлитые по всему животу;
- жидкий обильный пенистый стул со слизью или кровью.
Также возможно обезвоживание 1-3 степени тяжести.
Гастроэнтероколитический
Колитическая форма заболевания характеризуется:
- разлитыми болями в животе;
- стул с гноем, слизью, кровью.
Резкие спазмы и боль в сигмовидной кишке не определяются.
Гастритический
Гастрическая форма проявляется по типу всех пищевых бактериальных отравлений, но характер стула практически не изменяется. Выздоровление наступает в большинстве случаев через 2-3 дня.
Генерализованная форма
Данная форма возникает при тяжелом течении болезни, как правило, у маленьких детей и лиц преклонного возраста ввиду недостаточности иммунитета. Может протекать по тифоподобному варианту, или в виде сепсиса.
Тифоподобный
Начало заболевания проявляется поднятием температуры, рвотой, поносом, но затем появляются характерные признаки по тифозному статусу:
- брадикардия;
- гепатоспленомегалия;
- лихорадка в виде подъемов и спадов температуры.
Характерным проявлением тифоподобной формы являются высыпания на коже в виде розеол.
Септический
Данный вариант характерен в большей степени для грудных и новорожденных детей. Характерные признаки:
- лихорадка с ознобом;
- гепатоспленомегалия;
- развитие пневмоний;
- гнойная сыпь по всему телу.
У грудных детей могут наблюдаться судороги и тремор конечностей.
Бактериовыделительная разновидность
Иногда, несмотря на адекватную лечебную терапию, ребенок может остаться бактериовыделителем. Поэтому дети дошкольного возраста с признаками носительства остаются дома до полного избавления от сальмонелл.
Дети старшего возраста могут посещать школу после прекращения клинических проявлений заболевания.
Что представляет собой сальмонеллёз?
Как провести лечение
Процесс лечения назначается в зависимости от того, какой формой заболевания заразился малыш, насколько тяжело проходит болезнь, а также в зависимости от возраста пациента. В легких случаях доктор назначает лечение и отправляет больного домой, если случай тяжелый, то ребенка оставляют в стационаре на обследование и лечение. Стоит помнить, что даже легкая форма болезни требует от родителей точного соблюдения всех правил, которые указаны врачом.
Нельзя допускать обезвоживания организма малыша, поэтому важно использовать специальные растворы для восстановления солевого и водного баланса, а также давать ребенку пить больше жидкости.

Госпитализации в обязательном порядке подлежат те дети, которые сильно ослаблены. Также в больницу с сальмонеллезом определяют деток до трех лет, и при тяжелом течении заболевания. В больнице ребенку предоставляется индивидуальное питание, которое специально подобрано по диете. Также ребенку обеспечивают постельный режим, пациенту ставят капельницы, чтобы избежать обезвоживания, и используются препараты для выведения токсинов. Крайне редко врачи используют препараты, которые помогают уничтожать бактерии. Многие штаммы сальмонелл невосприимчивы к антибиотикам, поэтому такая терапия применяется очень редко.
Симптомы и признаки
Для развития заболевания у взрослых необходима большая доза бактерий. В то время как у детей достаточно небольшого количества возбудителя.
Инкубационный период заболевания может быть от нескольких часов до 2-3 суток. Попадая в организм человека, часть бактерий начинает разрушаться под действием желудочного сока, однако при их разрушении выделяется токсин, который и способствует развитию заболевания. Другая часть бактерий проникает по желудочно-кишечному тракту, дополняя симптоматику болезни. В области желудка и кишечника возникают схваткообразные боли, возникает рвота, понос, появляется слабость, головная боль.
Признаки развития недуга:
- У новорожденного появляются такие симптомы, как снижение аппетита, частые срыгивания, частый жидкий стул. Ребенок становится вялым. Температура тела в этот период, тем не менее, может оставаться нормальной. В связи с большой потерей жидкости симптоматика заболевания у новорожденных развивается очень быстро и состояние стремительно ухудшается. В этот период родителям необходимо обращаться за помощью как можно быстрее.
- Дети в возрасте от 2-х до 6-7 лет переносят заболевание значительно хуже. Основные симптомы это: высокая температура тела до 38,5-39°С, у малыша начинается озноб и лихорадка. Часто температура сопровождается поносом. Малыш чувствует острую боль в животе, появляются симптомы слабости, нарушается аппетит, появляется рвота.
Заболевание может быть легкой, средней и тяжелой степени. Все зависит от количества возбудителя, который проник в организм ребенка, и от его сопутствующих болезней (анемия, рахит, часто болеющие дети).
Диагностику сальмонеллеза и его отличие от других кишечных инфекций проводит врач. Для этого возьмут не только анализы крови и мочи, но и обязательно анализ кала. Если в анализах обнаружится данная бактерия, то будет выставлен диагноз сальмонеллеза. Иногда для оценки степени поражения организма необходим ряд дополнительных исследований, например, такие как УЗИ брюшной полости.
Первая помощь
При появлении у ребенка острой диареи, рвоты и высокой температуры тела рекомендуется обратиться в скорую помощь. До приезда бригады, чтобы избежать обезвоживания, следует давать теплую кипяченую или минеральную негазированную воду. Разрешается приготовить отвар ромашки, мяты. За счет большого количества жидкости организм будет выводить токсичные вещества.
Кроме этого необходимо принимать Регидрон, который помогает восполнить запас жидкости. Содержимое 1 пакета нужно растворить в 1 л воды. Приготовленную смесь можно хранить в холодильнике при температуре 2-8 °С до 24 часов.
В качестве дополнительных мер разрешается промывание желудка. Но этот метод подойдет только для детей старше 3 лет. С помощью процедуры можно облегчить общее состояние организма, вывести токсины.
Особенности промывания желудка при сальмонеллезе в домашних условиях:
- для очищения нужно 2-3 литра чистой теплой воды;
- ребенку дается выпить то количество жидкости, которое он может;
- нужно надавить двумя пальцами на корень языка, тем самым вызвав рвоту;
- процедуру выполняют до тех пор, пока рвотные массы не будут чистыми.
Признаки сальмонеллеза
Очагом патологии является желудочно-кишечный тракт. Пациенту характерно острое отравление от пищевых продуктов, или болезнетворная инфекция проникает в детский организм с грудным молоком. Преобладает обширная интоксикация печени и селезенки, поэтому даже новорожденному пациенту назначают антибиотики. Быстрым лечение сложно назвать, поэтому задача родителей – знать, как проявляется сальмонеллез – симптомы у детей. От наличия такого знания зависит клинический исход в конкретной клинической картине. Характерные признаки сальмонеллеза следующие:
- зловонный стул;
- изменение цвета и консистенции каловых масс;
- спазмы в животе;
- частые приступы рвоты, тошнота;
- повышение температуры тела.
Стул
Если развивается сальмонеллез – специфические симптомы у детей появляются спустя 1-3 суток с момента заражения бактериями. Прежде всего, это жидкий стул, в консистенции которого присутствуют кусочки непереваренной пищи. Это говорит о том, что пораженные органы пищеварения не справляются с полученной нагрузкой, наблюдается дисфункция ЖКТ. Стул при сальмонеллезе жидкий, имеет зеленоватый оттенок, может пениться, неприятно пахнет. Такой симптом сложно не заметить, тем более ситуация с каждым часом только усугубляется, при этом дополнена острыми приступами боли живота.
Сальмонеллез у детей – лечение
Несмотря на то, что сальмонелла – бактерия, антибактериальные препараты применяются лишь в случае генерализованных форм заболевания и назначаются исключительно врачом. Генерализованные формы нечасто встречаются у детей. Самые частые гастроинтестинальные формы лечат промыванием желудка и кишечника. Для этого назначаются препараты-сорбенты, для очистки кишечника используют клизмы.
- Восстанавливают водно-солевой баланс. Малышу предлагается дробное питье препаратов-электролитов (Хумана-электролит, Регидрон). В случае серьезных потерь жидкости назначают капельницы.
- Ферментные препараты дают хороший эффект при лечении гастроинтестинальных форм сальмонеллеза у детей.
- Придерживаются строгого режима питания. Диета при сальмонеллезе у детей направлена на создание максимально щадящего режима питания для желудка и кишечника.
Ограничивается потребление углеводов и жиров, сахара, питание дробное, 5-6 раз в день. Исключается горячая, холодная, острая, жирная, твердая пища, свежие фрукты и ягоды.
Современные методы лечения
После того, как врач определиться с точным диагнозом, характером течения заболевания и инкубационным периодом следует этап непосредственной терапии.
Характер лечения может отличаться в зависимости от возраста малыша и соответствующих особенностей заболевания: симптомов патологии и степень развития поражения.
Важно учитывать, что лечение в домашних условиях возможно, но с детским здоровьем лучше не рисковать. Лучше отправить ребенка в больницу, где ему обеспечат соответствующий присмотр, покой, постельный режим, необходимую диету и необходимые медикаменты
Основным методом терапии проблемы остается прием медицинских препаратов. Но, кроме антибиотиков и других лекарств, в терапии используют и другие вспомогательные средства.
Так в острой стадии развития заболевания, для того, чтобы предотвратить обезвоживание организма, больному прописывают чайно-водную паузу на десять часов. Так за это время пострадавший получает дневную порцию жидкости комнатной температуры. В случае развития рвоты или частом и жидком стуле также назначается капельная инфузия.
Несмотря на то, что все это можно сделать и дома, рекомендуется не рисковать и при подозрении на заболевание — обратиться к врачу. Это поможет избежать целого ряда неприятных последствия.
Посмотрим видео о лечении сальмоноллеза у детей:
Осложнения, которые могут возникнуть при сальмонеллезе у детей до года
Сальмонеллез – это инфекционное заболевание, которое может привести к серьезным осложнениям у детей до года. Особенно опасно это заболевание для новорожденных, так как их иммунная система еще не развита.
Кроме того, сальмонеллез может вызвать перитонит – воспаление брюшной полости. Это осложнение часто возникает у новорожденных, которые заражаются сальмонеллезом от матери во время родов.
Еще одним опасным осложнением при сальмонеллезе у детей до года является менингит – воспаление мозга и его оболочек. Это заболевание может привести к нарушению функций мозга и оставить непоправимые последствия.
Чтобы избежать осложнений при сальмонеллезе у детей до года, необходимо своевременно обращаться к врачу при появлении первых симптомов заболевания
Также важно соблюдать правила гигиены, особенно при приготовлении пищи и уходе за ребенком
Как помочь ребенку при заражении сальмонеллезом до года

При подозрении на заражение сальмонеллезом у ребенка до года необходимо обратиться в медицинское учреждение для проведения диагностики и назначения лечения. Самостоятельное лечение может ухудшить состояние ребенка и привести к серьезным осложнениям.
При лечении сальмонеллеза у детей до года важно следить за режимом питания и питьевого режима. Ребенку необходимо часто и по небольшим порциям давать грудное молоко или адаптированную смесь
Если ребенок отказывается от пищи, необходимо обратиться к врачу.
Помимо этого, врач может назначить антибиотики для борьбы с бактерией сальмонеллы
Важно строго следовать указаниям врача по дозировке и продолжительности приема лекарств
Важно также следить за гигиеной ребенка. Необходимо часто менять подгузники, проводить гигиенические процедуры и стирать белье при температуре не ниже 60 градусов
При своевременном обращении к врачу и соблюдении рекомендаций по лечению и уходу, ребенок быстро выздоравливает и восстанавливает свое здоровье.
Классификация
 Сальмонелла
Сальмонелла
Заболевание в зависимости от способов его распространения и участков поражения разделяют на четыре вида.
- Гастроинтестинальная форма. Является локализованной. Диагностируется практически в 97% случаев. В зависимости от того, где сосредотачивается возбудитель, различают:
- гастритический;
- гастроэнтеритический;
- энтероколитический;
- гастроэнтероколитический.
- Тифоподобная форма. Является генерализованной. Инфицируется не только кишечник, а также и остальные органы организма.
- Сепптическая форма. Также относится к генерализованным. Является наитяжелейшей формой недуга. Септические очаги возникают по всему организме.
- Бактерионосительство. Возбудитель обнаруживают исключительно при диагностических исследованиях. Специфическая симптоматика полностью отсутствует.
Формы
Сальмонеллез подразделяется на несколько форм в зависимости от места основного поражения.
Гастроинтестинальный сальмонеллез у детей

Проявляется у детей старше двух лет в виде колита, гастрита или гастроэнтерита. Новорожденные подвержены возникновению воспаления в желудке, тонком кишечнике. Форма может быть легкой или тяжелой.
Легкая форма чаще всего возникает у детей старшего возраста. В этом случае рвота появляется только вначале, температура невысокая, диарея около трех раз в сутки и проходит через 2 дня. Симптоматика уменьшается на 3 день.
Тяжелая стадия характеризуется диареей, которая может достигать 20 раз в сутки. Ее можно наблюдать в течение 4-5 суток. Возникает частая рвота, падает артериальное давление. От 3 до 5 дней у ребенка держится высокая температура и озноб. Выздоровление наступает не раньше чем через 14 дней.
Гастроинтестинальная стадия сальмонеллеза подразделяется на несколько видов:
- Гастрическая. Возникают симптомы, характерные для гастрита (тошнота, рвота, боли в желудке).
- Гастроэнтерическая. Появляется через 1-3 часа после проникновения возбудителя в организм. Характеризуется возникновением симптомов острого воспалительного процесса в кишечнике и интоксикацией. К основным признакам можно отнести изменения стула (имеет желто–коричневый или темно–зеленый цвет, неприятный запах, в каловых массах присутствуют частицы непереваренной пищи), тошноту, рвоту, боль в животе, повышенное газообразование, высокую температуру тела.
- Гастроэнтероколитическая. Характеризуется обильным жидким стулом зеленого цвета с кровью и слизью, сильной болью в области живота.
Генерализованный сальмонеллез у детей
Возбудитель поражает конкретный орган ребенка. Например, поджелудочную железу, сердце, сосуды, почки, печень. Главная особенность – это возникновение очагов гноя в органах.
У генерализованной формы сальмонеллеза имеется две стадии протекания:
- Тифоподобная. Появляется метеоризм, диарея, рвота, озноб. Допустимо возникновение аллергической реакции на кожном покрове, увеличение в размере печени и селезенки.
- Септическая. Чаще всего появляется у грудных детей. Возникает диарея, рвота, тошнота, повышается температура. Характеризуется усиленным потоотделением, ознобом, снижением артериального давления. Печень и селезенка увеличиваются в размере, возникают симптомы желтухи. Форма опасна вероятностью летального исхода.
Бактериовыделение
После того как ребенок выздоравливает, он становится переносчиком возбудителя сальмонеллеза. Острая фаза бактериовыделения по длительности может достигать 3 месяца. Присутствие возбудителей в организме ребенка дольше этого времени говорит о хронической форме сальмонеллеза.
Прочность иммунитета и возможность заражения
Дети, особенно младенцы, имеют более слабый иммунитет по сравнению с взрослыми. Именно поэтому у них повышен риск заражения сальмонеллезом. Организм детей еще не полностью сформирован, и он не всегда может эффективно справляться с инфекцией.
Риск заражения сальмонеллезом у детей может возникнуть в результате контакта с инфицированными продуктами питания, особенно если они не были должным образом приготовлены или хранились. Также дети могут заразиться, играя с инфицированными животными, особенно птицами и рептилиями.
Поскольку дети имеют слабый иммунитет, они часто развивают сильную симптоматику сальмонеллеза. У них может появиться высокая температура, обильное рвота и понос, а также слабость и потеря аппетита. Некоторые дети могут развить острую реакцию организма на инфекцию, что требует немедленного медицинского вмешательства.
Дети, страдающие хроническими заболеваниями, такими как иммунодефициты или болезни кишечника, могут быть более уязвимы для сальмонеллеза. В таких случаях лечение должно быть назначено и контролироваться врачом, чтобы предотвратить развитие осложнений и более серьезных последствий.
Причины заражения сальмонеллезом у детей:Симптомы сальмонеллеза у детей:
| Потребление неприготовленных или некачественных продуктов питания | Высокая температура |
| Контакт с зараженными животными | Обильная рвота и понос |
| Нарушение гигиены рук перед едой | Слабость и потеря аппетита |
Для профилактики сальмонеллеза у детей рекомендуется соблюдать правила хорошей гигиены, внимательно относиться к качеству продуктов питания и надлежащим образом их готовить. При появлении симптомов сальмонеллеза необходимо обратиться за медицинской помощью, особенно если речь идет о младенце или ребенке с хроническими заболеваниями.
Какими могут быть осложнения
Последствия данного заболевания для здоровья ребенка могут быть самыми разнообразными, все зависит от того, какой формой сальмонеллеза переболел малыш. Легкая форма обычно проходит без осложнений, если же заболевание перешло в тяжелую форму, то могут образоваться очаги воспаления в некоторых внутренних органах ребенка. Это очень часто происходит в том случае, если бактерии через кишечник проникают в кровь, а затем распространяются в другие органы.
У детей от года может развиться иммунодефицит, именно из-за этого может начать свое развитие повторная инфекция. Если же у ребенка имеются хронические заболевания, то они могут обостриться. Нередко врачи сталкиваются со случаями, когда последствия сальмонеллеза у детей вызывают развитие отита, ангины и пневмонии.
Все эти заболевания несут серьезную опасность для маленького организма, который сильно ослаблен после перенесенного сальмонеллеза.
Список других опасных осложнений:
- развивается отек легких;
- может возникнуть артрит и почечная недостаточность;
- возникает отек головного мозга и токсический шок.

Каждое из этих осложнений очень опасно для ребенка, так как может привести к летальному исходу. Именно поэтому необходимо вовремя провести диагностирование, а также лечение болезни. Нельзя запускать сальмонеллез, так как он требует правильного и своевременного лечения в любом возрасте. Кроме того, в период заболевания у ребенка возникает рвота и понос, а эти симптомы приводят к обезвоживанию детского организма, что также грозит смертью малыша.
Гастроинтестинальный тип: формы и симптомы
В этом виде сальмонеллез у детей встречается чаще всего и имеет три формы проявления. Степень тяжести заболевания зависит от масштаба заражения и нарушения водно-солевого баланса.
Общие симптомы желудочно-кишечного сальмонеллеза:
- повышение температуры тела, озноб, лихорадка;
- со стороны сердечно-сосудистой системы – тахикардия, пониженное артериальное давление;
- со стороны центральной нервной системы – головные боли, головокружение, судороги.
При гастроэнтеритной форме (у детей от 2 лет) наблюдаются боли в эпигастрии, метеоризм, тошнота, рвота, диарея (кал приобретает зелёный оттенок и водянистую структуру), налёт на языке и сухость слизистых. Температура поднимается незначительно.
Гастроэнтероколитная форма (до года) отличается от гастроэнтеритной значительным сокращением объема каловых масс, болезненной дефекацией с примесью крови и частыми ложными позывами. При пальпации живота прощупывается вздутие и спазм толстой кишки. Симптомы напоминают острую дизентерию.
Проявление заболевания в гастритной форме фиксируется крайне редко, но обнаружить его проще. Характеризуется резким началом, незначительной интоксикацией и отсутствием диарее. Протекает индивидуально, болезненные ощущения и вздутие сосредоточены в эпигастральной области.
Причины кишечной инфекции у детей
Спектр возбудителей кишечных инфекций у детей крайне широк. Наиболее часто патогенами выступают грамотрицательные энтеробактерии (шигеллы, сальмонеллы, кампилобактеры, эшерихии, иерсинии) и условно-патогенная флора (клебсиеллы, клостридии, протей, стафилококки и др.). Кроме этого, встречаются кишечные инфекции, вызываемые вирусными возбудителями (ротавирусами, энтеровирусами, аденовирусами), простейшими (лямблиями, амебами, кокцидиями), грибами. Общими свойствами всех возбудителей, обусловливающих развитие клинических проявлений, являются энтеропатогенность, способность к синтезу эндо- и экзотоксинов.
Заражение детей кишечными инфекциями происходит посредством фекально-орального механизма алиментарным (через пищу), водным, контактно-бытовым путями (через посуду, грязные руки, игрушки, предметы обихода и т. д.). У ослабленных детей с низкой иммунологической реактивностью возможно эндогенное инфицирование условно-патогенными бактериями. Источником ОКИ может выступать носитель, больной со стертой или манифестной формой заболевания, домашние животные. В развитии кишечной инфекции у детей большую роль играет нарушение правил приготовления и хранения пищи, допуск на детские кухни лиц-носителей инфекции, больных тонзиллитом, фурункулезом, стрептодермией и пр.
Наиболее часто регистрируются спорадические случаи кишечной инфекции у детей, хотя при пищевом или водном пути инфицирования возможны групповые и даже эпидемические вспышки. Подъем заболеваемости некоторыми кишечными инфекциями у детей имеет сезонную зависимость: так, дизентерия чаще возникает летом и осенью, ротавирусная инфекция – зимой.
Распространенность кишечных инфекций среди детей обусловлена эпидемиологическими особенностями (высокой распространенностью и контагиозностью возбудителей, их высокой устойчивостью к факторам внешней среды), анатомо-физиологическими особенностями пищеварительной системы ребенка (низкой кислотностью желудочного сока), несовершенством защитных механизмов (низкой концентрацией IgA). Заболеваемости детей острой кишечной инфекцией способствует нарушение нормальной микробиоты кишечника, несоблюдение правил личной гигиены, плохие санитарно-гигиенические условия жизни.




































